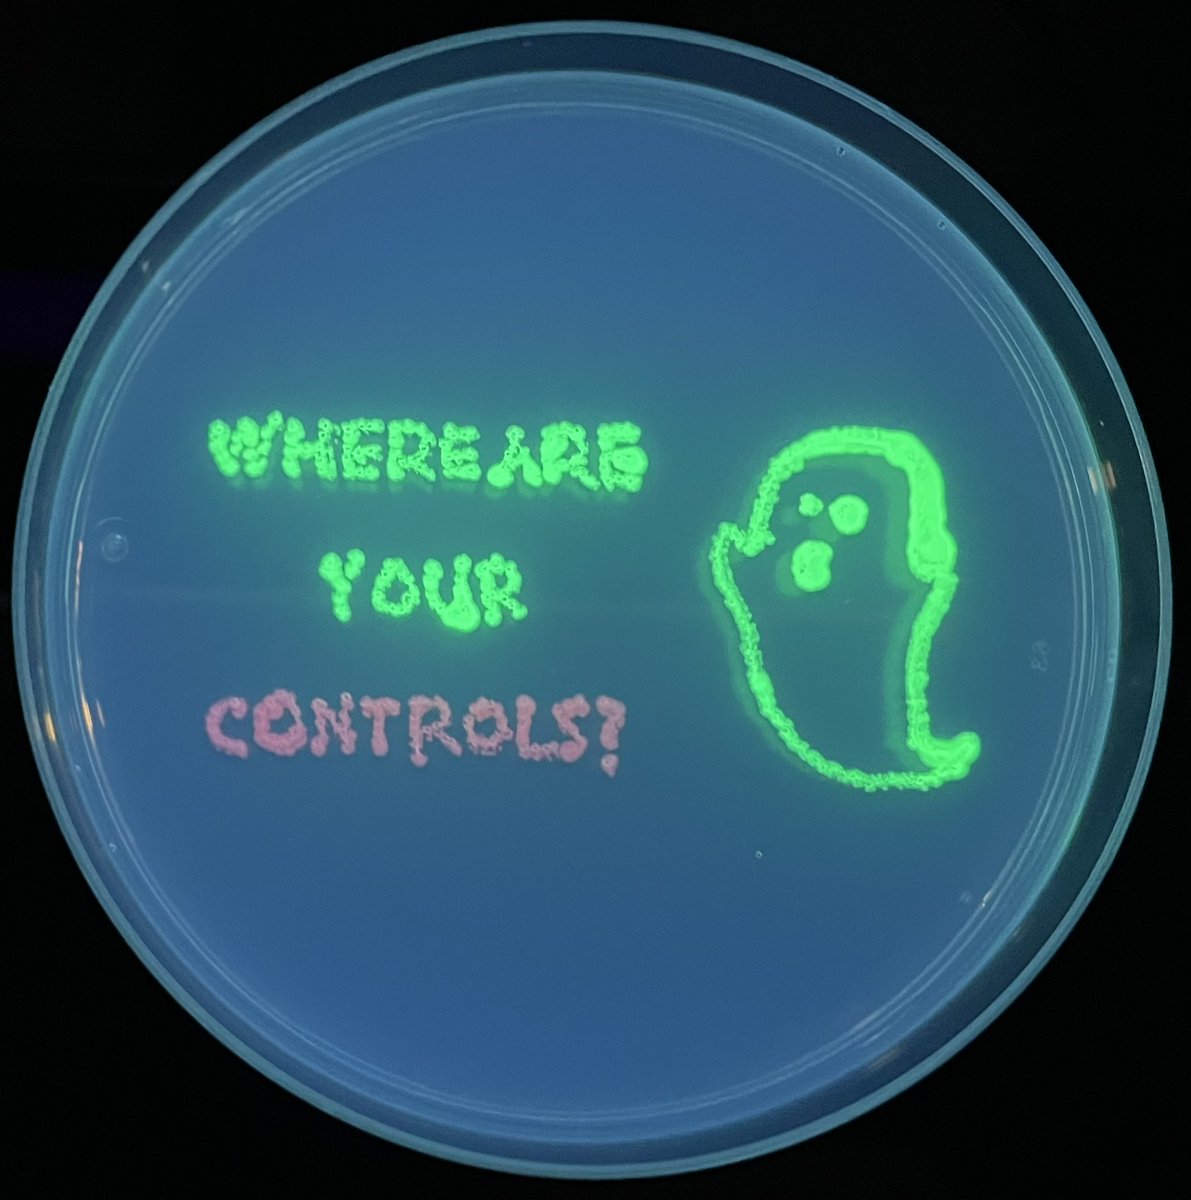

Anna Lena Jung
@evlunginfection
Scientist 🫁🦠🧬@uni_mr, extracellular vesicles in pneumonia
ID: 1580785093521690624
14-10-2022 04:58:53
137 Tweet
107 Followers
76 Following

The countdown has started for the 20th MBML Annual Retreat next week! MBMLProgram CPI The DZL Academy Universität Gießen @MizikIvana Stefan Hadzic Claudio Nardiello SCzarnecki Steven Corsello Tulane Department of Medicine Melissa Parke Charles A. Powell MD Shimoda Lab, EiC AJP-Lung AJP-Lung Cellular and Molecular Physiology Boehringer Ingelheim Paul G Thomas Darcy Wagner


#MBMLRetreat2024 is approaching! Check out all the details about our speakers and program at our webpage mbml67.wixsite.com/mbmlretreat2024 📣📣📣 CPI The DZL Academy Universität Gießen Steven Corsello Tulane Department of Medicine Melissa Parke Charles A. Powell MD Shimoda Lab, EiC AJP-Lung AJP-Lung Cellular and Molecular Physiology Boehringer Ingelheim Paul G Thomas Darcy Wagner




🫁 Aging impacts lung health in IPF and COPD. Our recent study shows how different triggers induce fibroblast senescence, impacting stem cell function. This opens new avenues towards #LungHealth #CureIPF #CureCOPD. Thank you to all the team! Mareike Lehmann doi.org/10.3390/cells1…


Forschungs-Highlight: Mit einem bestimmten #Risikomarker lässt sich die Schwere des Verlaufs einer #Lungenentzündung abschätzen, haben Forschende der #UniMarburg herausgefunden uni-marburg.de/awM1mQ UKGM Gießen und Marburg Foto: AL Jung


Schon mal📝vormerken🗓️12.09., 11-17Uhr: "Diffusible Signals in Microbiome Interaction" Symposium von LOEWE-Diffusible Signals an der Philipps Philipps-Universität, im @SYNMIKRO-Raum. Begrüßung+Schlusswort von LOEWE-🗣️Prof. Bernd Schmeck.Universität Gießen Max Planck Institute for Terrestrial Microbiology. Mehr hier⤵️#Hessen #Forschung


Thrilled to have spoken at the #GRC conference on #extracellularvesicles 🫧this week, thanks to Esther Nolte-'t Hoen ‘s invitation. Loved connecting with so many #EVenthusiasts! #GRC2024 #exofun



Bernd Schmeck iLung - Institute for Lung Research opens the PermedCOPD Symposium in Marburg! Great location at the cinema in downtown! Looking forward to listening the interesting talks! Interaktion_UMR Philipps-Universität


So many interesting talks in one day at the #PerMedCOPD symposium. Also, the venue is in a cinema with huge screen and excellent sound system. Such a unique experience! ☺️ More to come tomorrow! iLung - Institute for Lung Research Philipps-Universität @BMBF_Bund



Frachtgut kleiner Zellbläschen bietet neuen Behandlungsansatz bei Lungenfibrose: Forschungsteam um die Marburger Lungenforscherin Mareike Lehmann veröffentlicht Forschungsergebnisse gemeinsam mit Helmholtz Munich | @HelmholtzMunich und internationalen Partnern: uni-marburg.de/xLgF3w Mareike Lehmann

Marie won the publication award 🥇 at the German Society for Extracellular Vesicles meeting for our work on bacterial #extracellularvesicles 🫧 in response to last resort antibiotics 💉#proudpi 🥳 iLung - Institute for Lung Research


🚨 Job Alert 🚨 👉 Independent Junior Research Group Leader 👈 in the field of healthcare-associated #bacterial #pathogens. Apply before November 5 and RT! ▶️ cmfi.uni-tuebingen.de/en/career/open… DZIF (inaktiv) #jobs #hiring #career #sciencejobs


🌬️Excited to share our new publication on #COPD! Hendrik Pott found that changes in static hyperinflation and KCO% are markers of disease progression, predicting 3-year mortality. 🩺🔍 Our study reveals insights into disease activity and patient outcomes. 📊 Check it out 👇


We have two postdoc positions available (funded for 3 years by Volkswagen Momentum) for research related to the de novo evolution of (i) bacterial anti-CRISPR activities and (ii) archaeal tRNA gene introns. Please feel free to share or apply: stellenangebote.uni-marburg.de/jobposting/299…